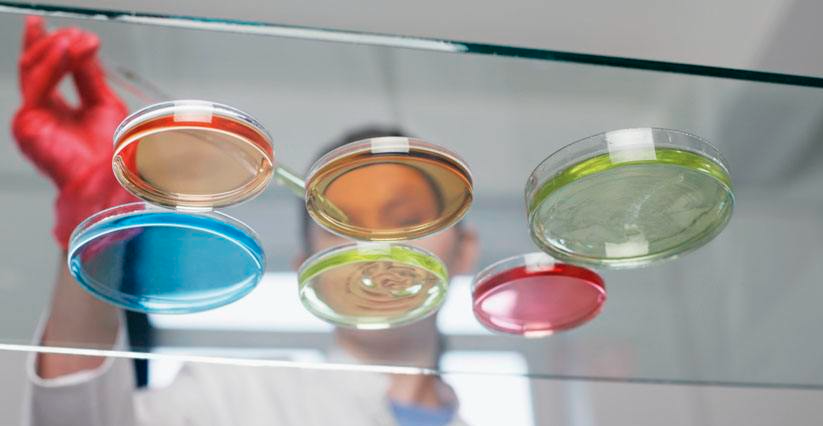
微生物培養(yǎng)基成分
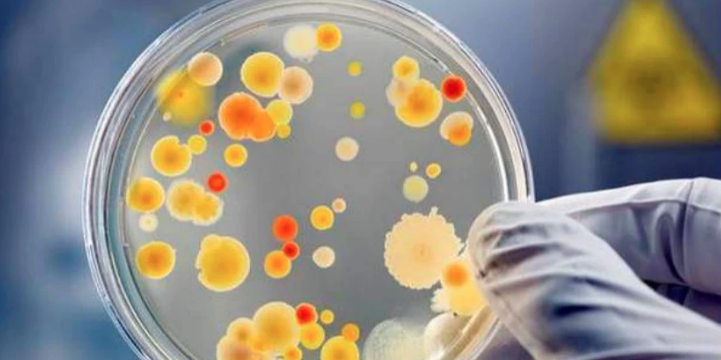
微生物培養(yǎng)基生長因子

微生物培養(yǎng)基中的生長因子指哪些,微生物培養(yǎng)基的碳源氮源無機鹽生長因子有哪些
發(fā)布時間:2022-02-21 瀏覽次數(shù):1497
微生物培養(yǎng)基(Microbial culture medium)是人工配制的適合微生物生長繁殖或積累代謝產(chǎn)物的營養(yǎng)基質(zhì)。任何培養(yǎng)基中均需含有微生物所必需的能源、碳源、氮源、礦質(zhì)元素、水和生長因素,但不同營養(yǎng)類型、不同種類的微生物對營養(yǎng)元素的要求又有很大差異。目前已使用的各種培養(yǎng)基都是前人經(jīng)過反覆實踐,比較設(shè)計的成果。
培養(yǎng)基的基本成分
能源、碳源:自養(yǎng)微生物以二氧化碳為碳源,光或無機物為能源,在無機物組成的培養(yǎng)基中生長。例如化能自養(yǎng)型的氧化硫桿菌培養(yǎng)基中,加入粉末狀硫為能源,以空氣中的CO2為碳源。
異養(yǎng)微生物以有機物為碳源和能源,培養(yǎng)基中常需加入葡萄糖、蔗糖或麥芽糖、乳糖等單糖或雙糖,有的可利用淀粉、纖維素等多糖,或利用動物組織中的糖類。例如培養(yǎng)細菌常用的牛肉膏蛋白胨培養(yǎng)基,其中牛肉膏即為主要碳源和能源。
氮源:自養(yǎng)微生物以含氮無機物銨鹽、硝酸鹽等為氮素營養(yǎng),例如氧化硫桿菌以(NH4)2SO4為氮源;異養(yǎng)微生物以無機物銨鹽、硝酸鹽或含氮有機物為氮源。自生固氮菌利用空氣中的N2為氮素營養(yǎng),其培養(yǎng)基中無須加入氮源,稱為無氮培養(yǎng)基。
礦質(zhì)元素、生長因子:微生物生長繁殖需要P、K、Na、S、Mg、Ca等主要礦質(zhì)元素以及Fe、Cu等微量元素,因此培養(yǎng)基中常加入K2HPO4、KH2PO4、MgSO4、NaCl、KCl、FeSO4等無機鹽類;生長因子主要是調(diào)節(jié)微生物代謝活動的B族維生素,常由酵母膏、肝浸出液等提供。許多天然成分的原料如牛肉膏、麥芽汁、玉米粉、豆芽汁等,含有各種無機元素和生長因子,不需另外添加。
培養(yǎng)基的類型 根據(jù)原料來源不同,可將培養(yǎng)基分為合成培養(yǎng)基、半合成培養(yǎng)基與天然培養(yǎng)基。
合成培養(yǎng)基:由化學(xué)成分已知的有機物和無機物配制而成。成分精確,重復(fù)性強。
但營養(yǎng)侷限,微生物生長緩慢。適用于菌種分離、選育、遺傳分析及生物測定等。如培養(yǎng)放線菌的高氏培養(yǎng)基、培養(yǎng)霉菌的察氏培養(yǎng)基以及各種化能自養(yǎng)菌培養(yǎng)基等。
半合成培養(yǎng)基:由某些天然物質(zhì)與少量已知成分的化學(xué)物質(zhì)配制而成。營養(yǎng)全面,能有效地滿足微生物對營養(yǎng)的需求。
廣泛應(yīng)用于微生物的培養(yǎng)。如培養(yǎng)細菌用的牛肉膏蛋白胨培養(yǎng)基,培養(yǎng)霉菌的土豆葡萄糖培養(yǎng)基,工業(yè)生產(chǎn)中常用的玉米粉等天然物質(zhì)加無機鹽配制的各種發(fā)酵培養(yǎng)基等。
天然培養(yǎng)基:由化學(xué)成分不清楚或不衡定的天然有機物配制而成。成分復(fù)雜,但營養(yǎng)豐富全面。常用于實驗研究和生產(chǎn)。如麥芽汁培養(yǎng)基、玉米粉培養(yǎng)基,以及生產(chǎn)中使用的麩皮、鋸末等。
根據(jù)培養(yǎng)基的物理性質(zhì),可分為液體培養(yǎng)基、固體培養(yǎng)基和半固體培養(yǎng)基。
液體培養(yǎng)基:用各種營養(yǎng)成分加水配成,或用天然物質(zhì)的浸汁(麥芽汁、豆芽汁等)制成。組分均一,適宜各類微生物的營養(yǎng)生長。
廣泛應(yīng)用于實驗研究及大規(guī)模工業(yè)生產(chǎn)中,有利于廣泛獲得大量菌體或代謝產(chǎn)物。
固體培養(yǎng)基:在液體培養(yǎng)基中加入凝固劑,或用麩皮等固體原料配制。常用的凝固劑是瓊脂(又稱瓊膠、洋菜),由石花菜等海藻中提取加工制成。
市售瓊脂為條狀、片狀或粉末狀,主要成分為多聚半乳糖的硫酸酯,絕大多數(shù)微生物不能將其分解,在培養(yǎng)基中僅起支撐作用。其熔點約98℃,凝固點42℃,1.5~2%的水溶液在一般培養(yǎng)溫度下呈凝膠狀態(tài)。
瓊脂固體培養(yǎng)基廣泛應(yīng)用于微生物的分離培養(yǎng)、菌種鑒定和保藏。
半固體培養(yǎng)基:液體培養(yǎng)基中加入0.2~0.5%瓊脂制成。用于觀察細菌的運動、菌種鑒定及測定噬菌體的效價等。
根據(jù)培養(yǎng)基的用途,可分為選擇培養(yǎng)基、鑒別培養(yǎng)基、加富培養(yǎng)基、基本培養(yǎng)基等。
選擇培養(yǎng)基:根據(jù)某一類或某種微生物的特殊營養(yǎng)要求而設(shè)計的培養(yǎng)基,用于提高所需微生物的分離效率。如分離固氮微生物的無氮培養(yǎng)基、加入濾紙條或纖維素粉為碳源分離纖維分解菌的培養(yǎng)基。
在培養(yǎng)基中加入某種化合物,可有效地分離出對這種化合物有抗性的微生物,例如在放線菌培養(yǎng)基中加入數(shù)滴10%的酚,可抑制細菌和霉菌的生長;加入一定量的青霉素、鏈霉素,可抑制細菌生長等。
鑒別培養(yǎng)基:根據(jù)微生物的代謝特點,在培養(yǎng)基中加入某種指示劑,通過顯色反應(yīng)以鑒別不同的微生物。例如檢查乳制品和飲用水中是否有腸道細菌污染所用的伊紅-美藍培養(yǎng)基。
當大腸桿菌等腸道細菌生長時,發(fā)酵培養(yǎng)基中的乳糖,使加入的伊紅-美藍變色,在菌落上沉積為紫黑色,并呈現(xiàn)金屬光澤。

培養(yǎng)基的制備方法 以下為常規(guī)方法,如配方中有特殊規(guī)定或要求,以配方為依據(jù)。
1,根據(jù)配方,計算各種營養(yǎng)成分用量。一般藥品可用普通藥物天平稱量,用量少的藥品,可按比例配成高濃度溶液,再按所需量用移液管吸取。稱好的藥品放入玻璃燒杯或搪瓷杯中。
2,在另一容器中將所需量的水(一般可用自來水,有特殊要求時需用蒸餾水)加熱,取全量的1/3左右倒入放藥品的容器中,用玻璃棒攪拌,待藥品全溶后,再將其余熱水全部倒入。
3,若配制固體培養(yǎng)基,則稱取1.5~2%的瓊脂放入已溶化的營養(yǎng)液中,繼續(xù)加熱至瓊脂全部溶解。
加熱中隨時攪拌,防止溢出或糊底。燒糊的培養(yǎng)基營養(yǎng)物質(zhì)破壞,并產(chǎn)生有毒物質(zhì),不宜再用。
4,待溶化的培養(yǎng)基稍冷卻后,按配方要求調(diào)整pH值。先取10毫升培養(yǎng)基裝入試管中,用pH試紙測其自然pH,再用1%NaOH(或1%HCl)調(diào)至所需pH,根據(jù)用量計算,換用10%NaOH(或10%HCl)調(diào)整所配全量培養(yǎng)基的pH。
加鹼(或酸)溶液時,應(yīng)邊滴加邊攪拌,至應(yīng)加量將近用完時,再次測試,最后調(diào)至要求的pH值。
5,配好的培養(yǎng)基,根據(jù)需要趁熱分裝至試管或錐形瓶中。分裝需用漏斗,以免瓊脂粘在管口或瓶口上。
裝瓶量一般為瓶容量的1/3~1/2;裝試管一般為試管高度的1/5~1/4,以免滅菌時培養(yǎng)基上溢,粘溼棉塞。
6,用預(yù)先制好的棉塞塞住管口或瓶口。棉塞既有利于通氣,又有濾菌作用,故松緊、大小應(yīng)適當,以免使用時影響操作(如圖)。
最后用牛皮紙或報紙包住棉塞,扎緊在瓶頸或試管上方,以免滅菌時水蒸汽沾溼棉塞或脫落。
7,滅菌后取出的固體培養(yǎng)基,根據(jù)需要可將試管立即斜放,冷凝后即成斜面培養(yǎng)基,用于菌種擴大培養(yǎng)及保藏;錐形瓶中的培養(yǎng)基,倒入無菌培養(yǎng)皿中,冷凝后即制成平板培養(yǎng)基,可用于菌種的分離、鑒定等。液體培養(yǎng)基冷卻后可直接根據(jù)需要接入菌種。
